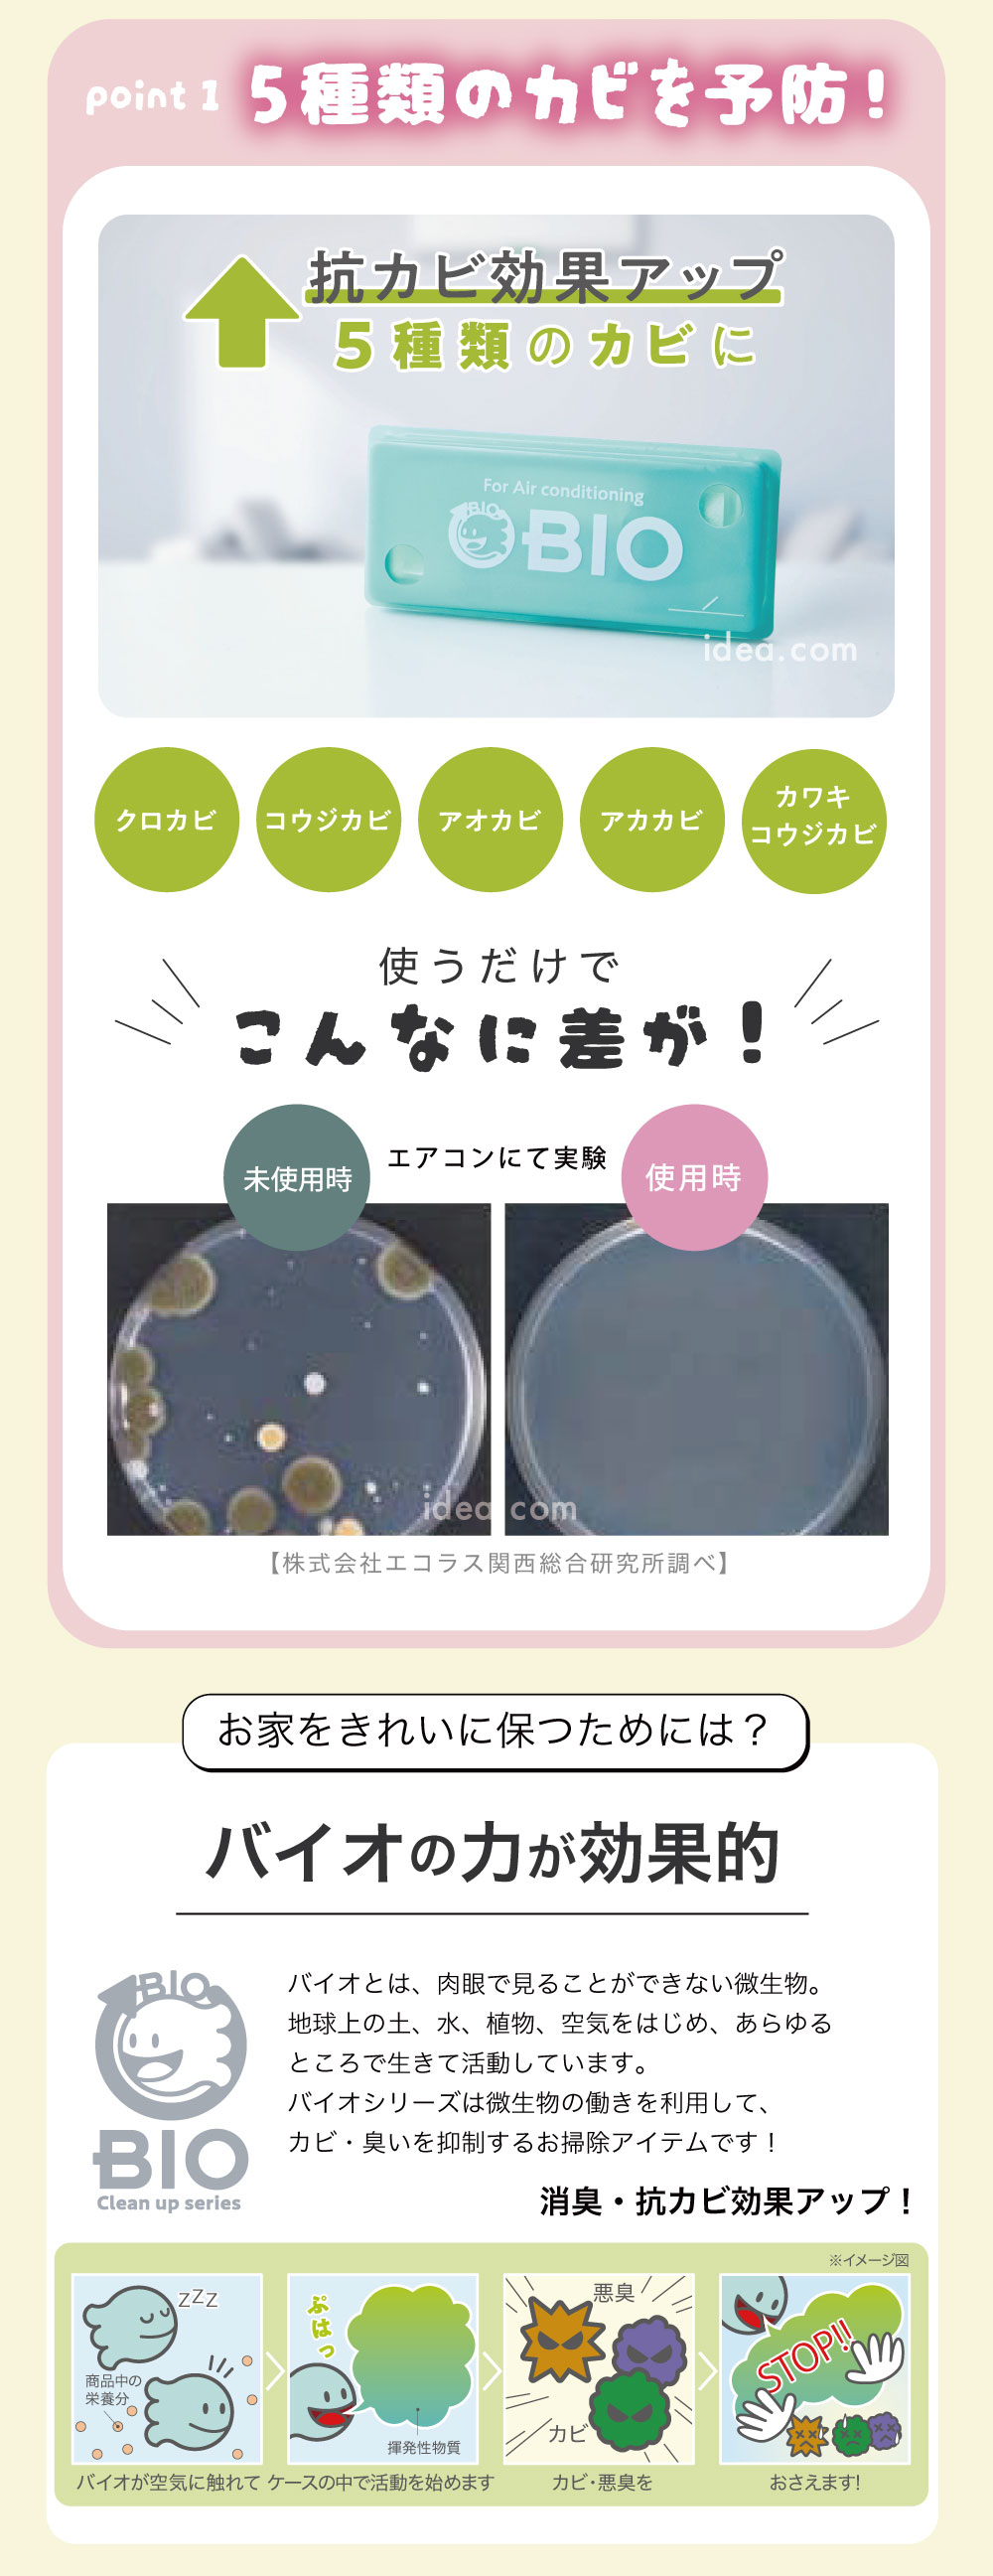

【希琳選物】Bio空調防霉盒(標準版)
日本Bio-空調防霉盒(標準版)
【只要貼在進風口,冷氣吹出的霉味交給它清光光】
是時候換個方式了!與其等發霉了才花大錢清洗,不如從日常「預防」做起。這款來自日本 Cogit 的升級版「Power Bio 冷氣防霉盒」,利用大自然微生物的力量,只需貼在冷氣上方進風口,就能讓好菌隨風深入機體內部,為您的冷氣打造長達 3 個月的隱形防護罩。
✨ 四大亮點,懶人必備的冷氣防霉神器
1. 升級版 High Power 菌種,防護力再進化。相較於舊款,新款採用了更強效的微生物菌株。不僅能抑制常見的黑霉,更能深入冷氣內部,有效對抗多達 5 種常見的霉菌。讓防霉效果更全面、更有感,從源頭淨化吹出來的冷風。
2. 貼在進風口,深入機體零死角 為什麼要貼在上方進風口?因為冷氣運作時會從上方吸入空氣,Bio 微生物便會跟著氣流被吸進冷氣內部,均勻覆蓋在冷排、風扇等平時手伸不到、刷不到的死角,全方位抑制霉菌孢子落地生根。
3. 抗菌兼消臭,室內空氣變清新 不僅防霉,它還能有效分解冷氣機內積聚的難聞霉味與悶臭味。不使用刺鼻的化學香精強行掩蓋,而是從根源瓦解異味,讓冷氣吹出的風隨時保持自然的潔淨感。
4. 效力長達 3 個月,省時又省錢 安裝一次,就能持續守護冷氣約 3 個月(足以涵蓋整個夏季)!平均下來每天只需銅板價,就能大幅延長冷氣需要請人深度拆洗的週期,省下高昂的清洗費,更守護了全家人的呼吸健康。
💡 適用對象
> 討厭冷氣霉味的人:一開機就容易打噴嚏,對室內異味極度敏感。
> 家有過敏兒/長輩/寵物:需要純淨的空氣,不想依賴化學除霉除臭劑。
> 難以自行清洗冷氣的人:希望減少請專人來拆洗冷氣的頻率與花費。
> 剛清洗完冷氣的家庭:強烈建議!趁著內部最乾淨時立刻安裝,維持無霉的極淨狀態。
📝 超簡單!三步驟使用教學
1. 【清潔】:建議先將冷氣機外殼與濾網清洗乾淨,並擦乾進風口處的水分與灰塵。(本產品為預防霉菌生長,若機體內部已有嚴重厚重黑霉,建議先請專人清洗後再使用以達最佳效果)。
2. 【黏貼】:撕開背膠,將防霉盒黏貼在冷氣機上方的進風口處。
3. 【紀錄】:寫下更換日期在防霉盒上,之後正常使用冷氣即可!
(※小提醒:使用期間請勿在冷氣周遭使用具殺菌效果的噴霧、強效化學清潔劑或燻煙式殺蟲劑,以免殺死好菌。)
這是一款「用過就會回購」的神奇好物。它默默地在冷氣上方工作,您可能看不見它在做什麼,但幾個月後您會驚訝地發現:「奇怪,為什麼今年夏天吹冷氣,都沒有那股討厭的霉味了?」
把化學除臭劑丟掉吧,讓 Bio 替您守護室內空氣的潔淨與健康!
註: 本商品進口數量有限,若已售完,且可同意等到貨後再寄貨,那請選擇預購方式訂購,約9~14天即可收到(主要還是看當下貨運公司狀況)。若有其他疑慮,還請透過官方line@與我們聯繫,謝謝。